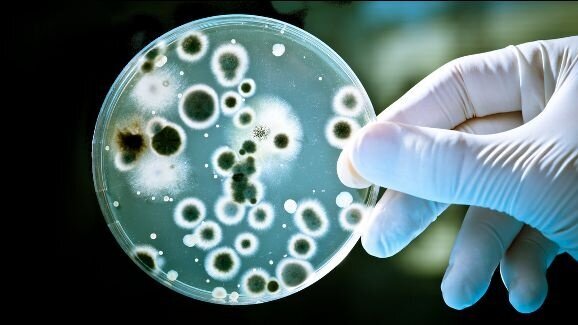
Бактериите, причиняващи пародонтит – манипулация на имунната система

Ново проучване от САЩ дава доказателства за това, че Porphyromonas gingivalis, основен патоген на хроничното възпалително заболяване пародонтит, също така манипулира човешката имунна система. В редица лабораторни тестове учените наблюдават как патогенът инхибира защитните процеси на тялото, които иначе би трябвало да го унищожат.
С цел да се открие по какъв начин P. gingivalis повлиява имунната система, учените обработили миши клетки с антитяло срещу интерлевкин-10 (IL–10), противовъзпалителен протеин. В същото време друга проба с клетки е оставена необработена. След това е проверено дали клетките продуцират γ-интерферон (IFN–γ), белтък, който има имуностимулиращ и противовирусен ефект.
Според проучването P. gingivalis стимулира продукцията на IL-10 и предизвиква потискане на дейността на Т-клетките и макрофагите, а оттам – на имунния отговор. Учените наблюдавали повишена продукция на IFN–γ при третираните клетки, а в останалите това не е наблюдавано.
Изследването подчертава механизма, по който патогенът изгражда среда за хронична инфекция.
„Тези бактерии не просто преодоляват имунната ни защита; те всъщност я манипулират, за да осигурят собственото си оцеляване“, казват учените. Резултатите показват, че уврежданията, причинени от бактериите, се случват тогава, когато имунните клетки на организма са изложени на действието на патогена. С оглед на успешното лечение резултатите демонстрират важната роля на ранното вземане на мерки.
Според Centers for Disease Control and Prevention един от всеки двама американци на възраст над 30 години има пародонтит. И тъй като заболяването често е труднолечимо, учените се надяват, че получените резултати могат да предотвратят или променят протичането на хроничните инфекции, причинени от патогена.
Изследването е проведено в Бирмингамското дентално училище към University of Alabama и е публикувано в януарското издание на Journal of Leukocyte Biology.
Изследователи във Финландия са проучили ролята на бактерия, пряко свързвана с ...
Когато оралните бактерии, разнасяни чрез кръвта, инвазират други тъкани, резултатите...
Учени от денталния факултет към Indiana University в момента разработват нови биоматериали, ...
Приемът на витамин D се превърна в противоречив въпрос. Проучванията показват ...
Нов механизъм за предупреждение цели да подобри прозрачността в денталната медицина...
Според предварително проучване лечението на пародонтита значително намалява ...
Според неотдавнашно проучване, проведено от Ирландската дентална асоциация (IDA), ...
МАЯМИ, САЩ: Yomi – подпомагано от роботи хирургично устройство, разработено от ...
Според Американската асоциация на ортодонтите само в САЩ и Канада повече от пет ...
През април 2017 г. Европейският парламент одобри нов регламент за медицинските изделия...
Уебинар на живо
пн. 6 юли 2026
7:00 (EET) Sofia
Уебинар на живо
ср. 8 юли 2026
3:00 (EET) Sofia
Dr. Mark Donaldson BSP, ACPR, PHARMD, FASHP, FACHE
Уебинар на живо
ср. 8 юли 2026
3:00 (EET) Sofia
Уебинар на живо
ср. 8 юли 2026
8:00 (EET) Sofia
Prof. Gianluca Gambarini MD, DDS
Уебинар на живо
чт. 9 юли 2026
5:00 (EET) Sofia
Dr. Jae Seon Kim DDS, MSD, FACP, CDT
Уебинар на живо
чт. 9 юли 2026
8:00 (EET) Sofia
Dr. Armando Lopes, Dr. Carlos Moura Guedes
Уебинар на живо
пт. 10 юли 2026
3:00 (EET) Sofia



 Австрия / Österreich
Австрия / Österreich
 Босна и Херцеговина / Босна и Херцеговина
Босна и Херцеговина / Босна и Херцеговина
 България / България
България / България
 Хърватия / Hrvatska
Хърватия / Hrvatska
 Чехия & Словакия / Česká republika & Slovensko
Чехия & Словакия / Česká republika & Slovensko
 Франция / France
Франция / France
 Германия / Deutschland
Германия / Deutschland
 Гърция / ΕΛΛΑΔΑ
Гърция / ΕΛΛΑΔΑ
 Унгария / Hungary
Унгария / Hungary
 Италия / Italia
Италия / Italia
 Нидерландия / Nederland
Нидерландия / Nederland
 Скандинавия / Nordic
Скандинавия / Nordic
 Полша / Polska
Полша / Polska
 Португалия / Portugal
Португалия / Portugal
 Румъния & Молдова / România & Moldova
Румъния & Молдова / România & Moldova
 Словения / Slovenija
Словения / Slovenija
 Сърбия & Черна гора / Србија и Црна Гора
Сърбия & Черна гора / Србија и Црна Гора
 Испания / España
Испания / España
 Щвейцария / Schweiz
Щвейцария / Schweiz
 Турция / Türkiye
Турция / Türkiye
 Великобритания и Ирландия / UK & Ireland
Великобритания и Ирландия / UK & Ireland
 Международни / International
Международни / International
 Бразилия / Brasil
Бразилия / Brasil
 Канада / Canada
Канада / Canada
 Латинска Америка / Latinoamérica
Латинска Америка / Latinoamérica
 САЩ / USA
САЩ / USA
 Китай / 中国
Китай / 中国
 Индия / भारत गणराज्य
Индия / भारत गणराज्य
 Пакистан / Pākistān
Пакистан / Pākistān
 Виетнам / Việt Nam
Виетнам / Việt Nam
 АСЕАН / ASEAN
АСЕАН / ASEAN
 Израел / מְדִינַת יִשְׂרָאֵל
Израел / מְדִינַת יִשְׂרָאֵל
 Алжир, Мароко и Тунис / الجزائر والمغرب وتونس
Алжир, Мароко и Тунис / الجزائر والمغرب وتونس
 Близкият Изток / Middle East
Близкият Изток / Middle East

To post a reply please login or register